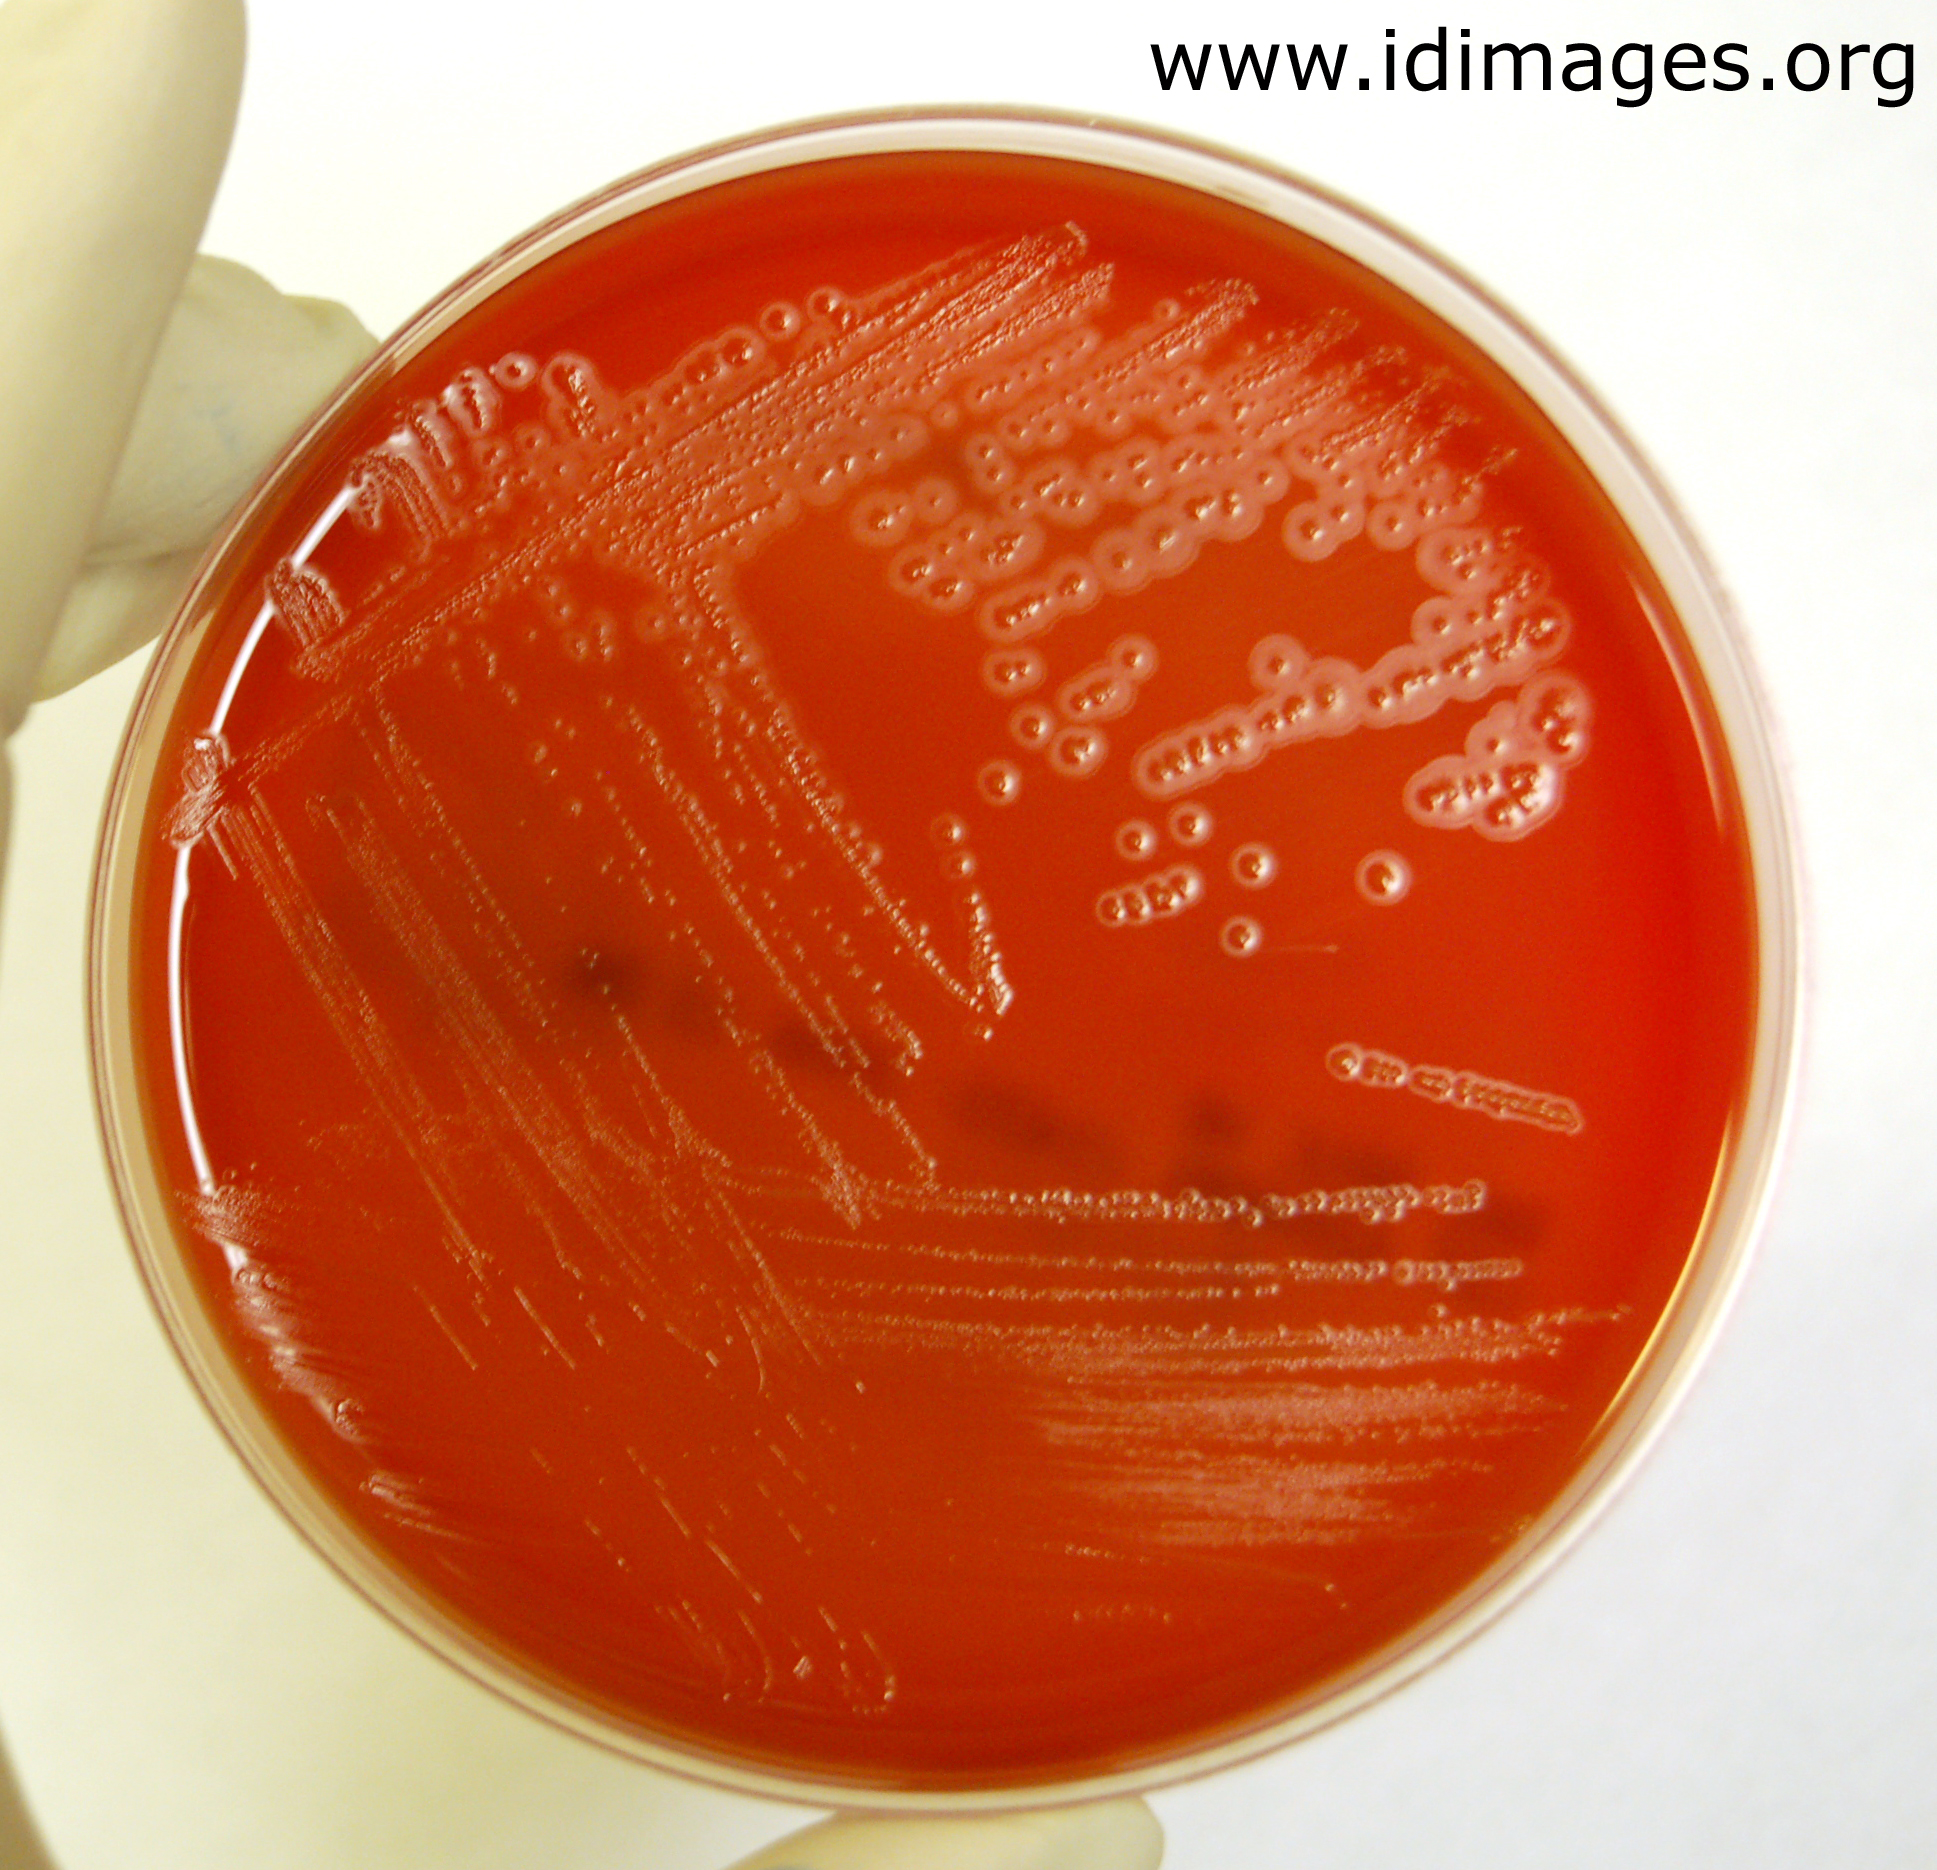

Kingella spp
А я люблю лето шоколадного цвета песня
Текст моргенштерна я когда нибудь уйду
Русфарм сайт
Stray kids chk chk boom транскрипция текст
Инженер инженеру 7 букв
Я уже забыла о чем
Мальчишка из моего детства
Значение имени ларс
Включи фони бобби в гаррис моде
Перевод баллов егэ в оценки таблица
Я буду скучать по тебе друг
Смывка лимоном
Образец доверенности на предоставление интересов физического
Kingella spp 105 фото